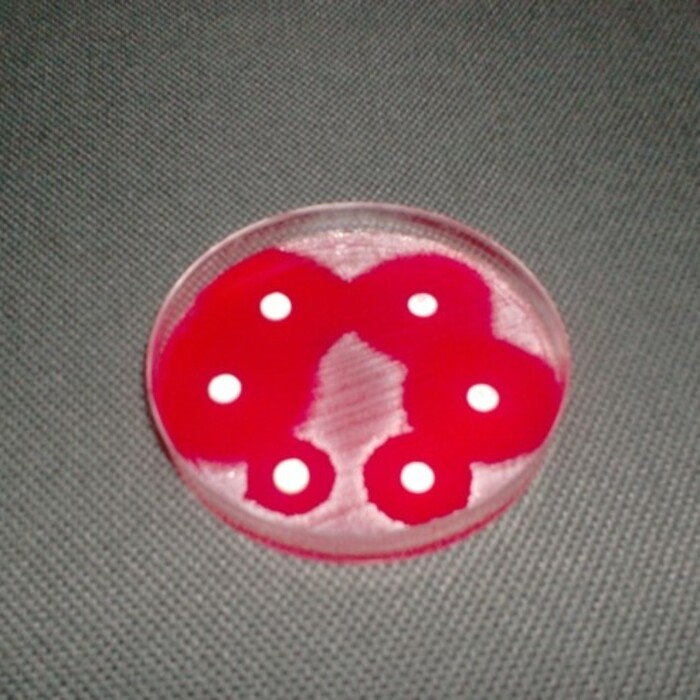
picture1_700x700_crop_478b24840a

Антибиотици, Антибиотична резистентност и Антибиотична политика
На 18 ноември 2021 г. департамент „Природни науки“ отбеляза в рамките на семинар „Микроорганизмите и ние“ Европейския ден на антибиотиците. СЗО е определила седмицата 18–24 ноември за Световна седмица на осведомеността относно антибиотиците. Модератор на семинара бе проф. Емма Кьолеян, д.м.н., преподавател в МП „Микробиология“. Студентите представиха доклади на разнообразни теми като: Антибиотична резистентност на избрани инфекциозни причинители, Карбапенем резесистентни Enterobacterales, Сексуално-преносими инфекции и микробиологичната им диагноза, Новите антибиотици, Мултирезистентност на Acinetobacter baumanii.
Откриването на антибиотиците е сред най-големите достижения на съвременната медицина. Те лекуват сериозни инфекции, предпазват от усложнения и инвалидизиране, спасяват човешки животи.
Терапията с антибиотици понастоящем се затруднява от развитието и бързото разпространение на антибиотичната резистентност. Някои микроорганизми са устойчиви на почти всички антибиотици и антибиотичната резистентност е обявена за глобална заплаха от СЗО.
Основната причина за възникване и разпространение на резистентността е излишното и неправилно прилагане на антибиотиците. Усилията на медицинската общност са насочени днес към Рационална антибиотична политика (Antimicrobial stewardship), целяща пациентът да получи най-подходящия антибиотик и да бъде забавена антибиотичната резистентност.
Студентите от МП „Микробиология“ в курса по Медицинска бактериология внесоха своя принос в повишаването на знанията за антибиотиците и антибиотичната резистентност, подготвяйки тематични презентации.
Снимка: доц. д-р Галина Сачанска, съвместно с проф. Енчо Савов в катедрата по Клинична микробиология на ВМА